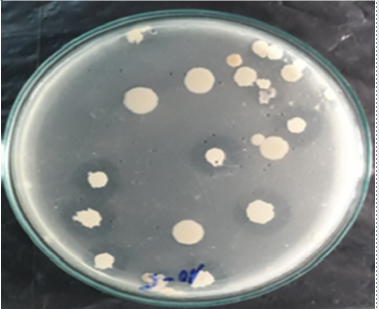

Hong Thi Thu Phan, Ngan Thi My Luong, Trung Tien Vu, Ho Thanh Pham, Huy Thuc Ha, Nhan Thuc Chi Ha
Nguyen Thuy Huong, Tran Thi Tuong An
Bach Ngoc Minh

Aishwariya Sachidhanandham, Priyanka M

Mujeeb ur Rahman, Amir Ullah, Haroon Haroon, Muhammad Bilal, Fazal Mehmood Khan, Muhammad Naveed
Lan Thi My Nguyen, Linh Thi Phuong Huynh, Phuoc Thi My Le, Hien Quoc Nguyen

Thi Thanh Tam Phan, Thi Phuong Thao Nguyen, Tin Dai Luong, Kieu Thi-Thuy Nguyen, Thao Nhi Dang Ngoc, Hiep T Nguyen
Phien Van Pham, Huong Thuy Nguyen

Kieu Thi-Thuy Nguyen, Thao Thi-Phuong Nguyen, Huy Hoang Nguyen, Tin Dai Luong, Thai Anh Huynh, Khue Le-Minh Tran, Bao Gia Nguyen, Hai Huu Nguyen, Thu Ngoc-Minh La, Hai Do-Quoc Nguyen, Hoan Ngoc Doan, Hiep T Nguyen
Thang Luong Pham, Trang Thi Phuong Phan, Thuoc Linh Tran, Hoang Duc Nguyen